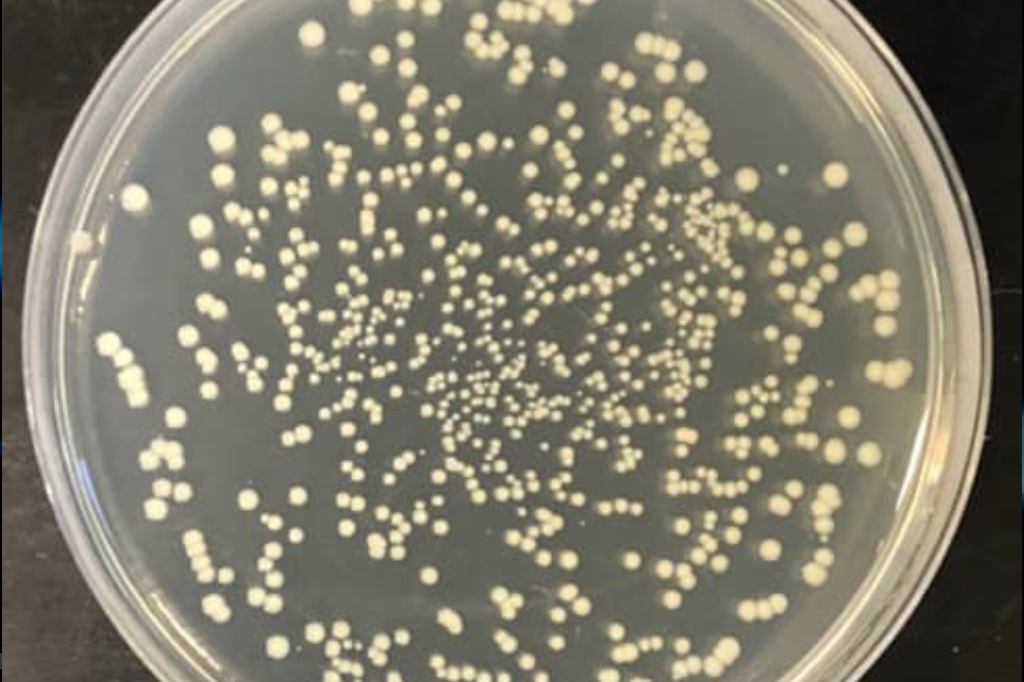
bacteria
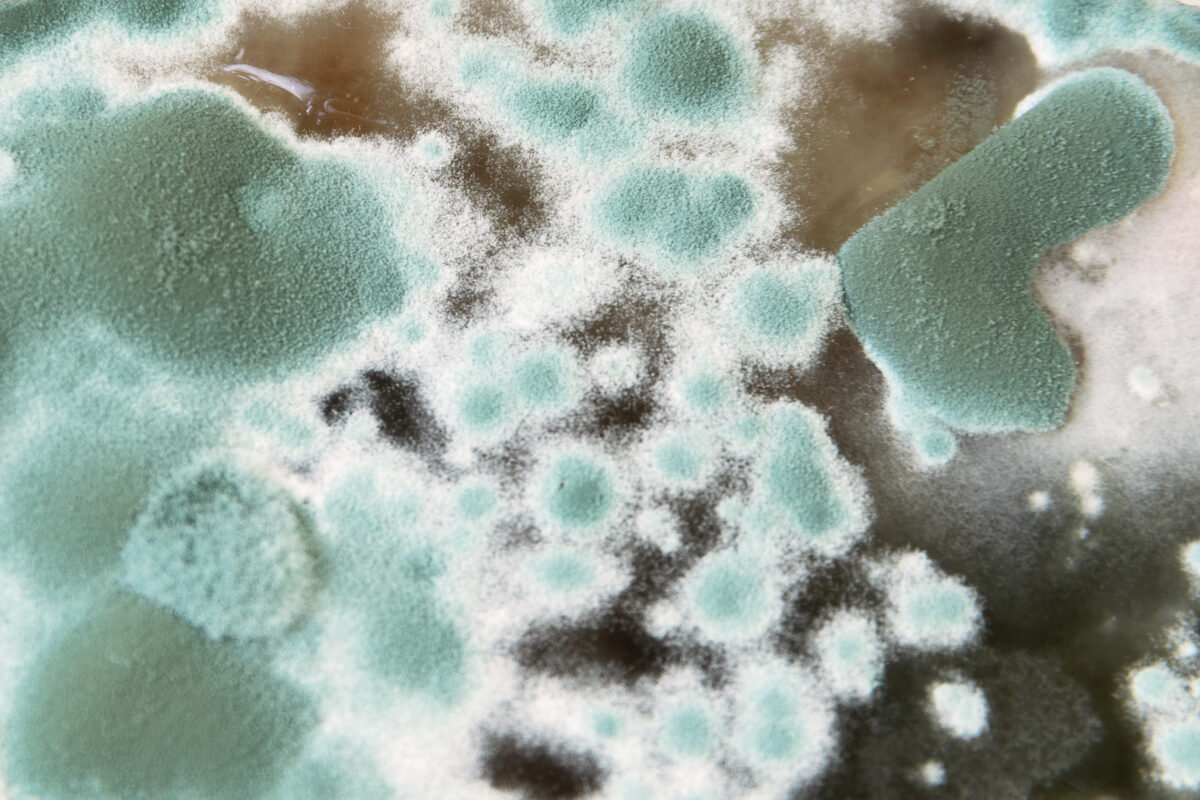
Texture of mold and fungi, microbiology, abstract background

Copper’s antimicrobial capacity is nothing short of exceptional.
Copper prevent microbial insult, halt the generation of yeast and mold, and make the world safer and healthier. Copper remains effective across wide-ranging conditions, including in hot and humid environments. Copper is also the sole metal which is an antimicrobial agent and an essential micronutrient for humans and other living organisms.
Copper Technology is Effective Against:

Viruses
Such as HIV, Influenza, Coronavirus 229E, COVID-19, and others.
Bacteria
Including both gram-negative (E.g. E. coli, Klebsiella pneumoniae) and gram-posivitive (E.g. Seaphylococcus (MRSA), Enterococcus (VRE)) bacteria.

Algae
Such as Gloeocapsa, a cyanobacteria (blue green algae)
Fungi
Such as Trichophyton mentagrophytes, Canadida spp, and others.

Spore Germination
Aspergillus niger and others

Biofilm Formation
Such as Streptococcus sanguis, and others.
Cupron Copper’s Antimicrobial Mechanisms:
- Oligodynamic Effect
- Electron Release
- Plasma Membrane Permeabilization
- Membrane Lipid Peroxidation
- Nuclear Acid Damage
- Intracellular Protein Assembly and Activity Inhibition
Marketing claims for Cupron Enhanced partner products are regulated according to the products, uses and geography. Cupron makes no product specific claims as a part of this technology overview. See finished partner products for appropriate product marketing claims.